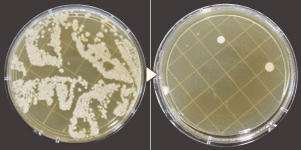
4th_en_electrolysis_7 4th_en_electrolysis_7

守る水 電解水
細菌への防衛力なら「電解水」
細菌への対策として有効な
手段が「電解水」です。
洗浄力の「アルカリ性電解水」
除菌力の「酸性電解水」
電解水の二つのチカラが、細菌を除去した
真の「清潔」を実現します。
電解水に必要なのは
「水」と「塩」と「電気」だけ
電解水の生成に特別な原料は必要ありません。必要なのは「水」と「塩」と「電気」だけ。水道水に含まれるミネラルやチリ、ゴミ等を軟水器とフィルターを通して除去。この水と塩水を電気分解することにより、「強アルカリ性電解水」と「強酸性電解水」が生成されます。
マイナス(-)の電極側から洗浄力の高いpH約12.0の強アルカリ性電解水と、プラス(+)の電極側から除菌力の高いpH約3.0(有効塩素濃度20~70ppm)の強酸性電解水が生成されます。
洗浄&除菌
W効果の電解水で汚れの中に
潜む菌も効果的に除去
「菌が汚れの中に潜んでいる場合、通常の除菌剤だけでは菌を覆っている汚れに
ガードされてしまい、充分な除菌効果を発揮することができません。
そこで、洗浄力&除菌力、W効果の「電解水」
まず「アルカリ性電解水」で、細菌の温床や臭いの元となる
たんぱく質・油脂汚れを分解洗浄。その後「酸性電解水」で菌を除去します。
![]() |
![]() |
![]() |
||
アルカリ性電解水洗浄。 |
酸性電解水洗浄。 |
食中毒/院内感染対策電解水を
洗濯水として使用した際の除菌効果
弱酸性電解水に含まれる次亜塩素酸が高い除菌効果を発揮し、洗濯しながら除菌します。
| おむつカバー | |
|---|---|
| 除菌前 | 除菌後 |
![]() |
|
| 下着 | |
|---|---|
| 除菌前 | 除菌後 |
![]() |
|
食中毒/院内感染対策
さまざまな脅威を招く病原菌を除菌
酸性電解水が食中毒の原因となる大腸菌やサルモネラ菌
黄色ブドウ球菌、腸炎ビブリオ菌などを除菌します。
| さまざまな脅威を招く病原菌を除菌 | ||
|---|---|---|
| 除菌できる病原菌 | 大腸菌,O-157,O-111[食中毒] | リステリア菌[食中毒] | 黄色ブドウ球菌 [食中毒] |
| サルモネラ菌[食中毒] | MRSA[肺炎] | 腸炎ビブリオ[食中毒] |
| セレウス菌[食中毒] | 溶血性連鎖球菌 [皮膚疾患] |
緑膿菌[下痢] |
| 赤色酵母[水まわりの赤色発色 真菌] | カンピロバクター [食中毒] |
レジオネラ菌[肺炎] |
活用事例
食の安全、電解水が守ります。
食の安全が叫ばれて久しい昨今ですが、それでもなお、食中毒の発生件数は一向に減る気配を見せません。
細菌やウイルスから身を守るには「食中毒予防の3原則(菌を付けない、増やさない、除去する)」や「食品衛生7S(整理・整頓・清掃・洗浄・殺菌・しつけ・清潔)」を踏まえ、環境衛生についての徹底した施策が重要です。
これをサポートするのが電解水の洗浄・除菌効果。調理場・調理器具から、食材・食品の保管スペースまで。食にまつわる衛生管理に、電解水が活躍します。
年齢とともに低下する免疫力。
補うのは「衛生力」
腸管出血性大腸菌O-157やサルモネラなど、少数の菌でも感染・発症に至る感染型食中毒の集団発生が高齢者施設で多く見られます。
高齢者は基礎疾患を持ち、あるいは免疫力の低下している方が多いために、どうしても感染の危険性が高くなることが否めません。そこで、電解水。衣類やシーツの洗濯をはじめ、食器・食材、介護用具、来訪者・職員の手指洗浄まで、生活空間としての施設全体を電解水の衛生力がカバーします。
しかも、既存の消毒液などのような「薬液」でないために高齢者施設でも安心して使用できます。
不特定多数の人々が集まる空間は
菌も不特定多数
ビル、ホテル、商業施設、駅。不特定多数の人が集うパブリックスペースにおいては、往来する人数の増加に比例して菌との接触確率も必然的に高まります。だからといって、ある空間において病原菌の保菌者を即時に特定し隔離することは事実上不可能。施設管理者にできうる現実的な対策は、その空間を最大限「清潔」に保つこと。その要求に電解水の洗浄・除菌効果が応えます。また、電解水を使った清掃なら二度拭きが要らず、清掃の手間も省け、効率よい清掃作業が実現。管理する場所が多ければ多いほど、電解水が役立ちます。
畜産・農業・水産。
生産地点からの衛生管理を
牛乳に限れば、過去に発生した大規模な食中毒事件を例にすると、製造加工工場での菌汚染がその原因でした。しかし、その前段階、生産者における環境衛生も当然ながら重要です。わずか乳牛1頭あるいは搾乳器1台の菌汚染であったとしても、その後、牛乳の経路となる貯留用タンク・運搬用タンク・工場において他の牛乳と混じることで「交差汚染」を招く恐れがあります。生産の最上流地点から、菌を排除する。しかも、健康被害の恐れのある薬品などは用いず、安全に。その課題を電解水が解決します。
湿度・温度・汗・・・。
菌が好む環境にこそ、電解水を
重症肺炎を引き起こし、死に至る危険性のあるレジオネラ症。その原因菌であるレジオネラ属菌は、循環式浴槽、冷却塔など、温かく栄養分のある水が循環している設備の中において非常に高い繁殖率を示します。なぜならこれらの設備では生物膜(いわゆる「ぬめり」)が発生しやすく、レジオネラ属菌はこの生物膜に生息するアメーバに寄生して増殖するためです。このレジオネラ属菌対策に有効なのが、電解水。まず、アルカリ性電解水が菌の温床となるぬめりを洗浄。続いて、酸性電解水で菌そのものを除去。浴場から送水用配管まで、幅広く使用できます。
製品仕様・諸元
ESS−300
アルカリ性電解水 貯留タンク 300L酸性電解水 貯留タンク 300L
※洗濯機本体はシステムに含まれておりません。
| ESS−300 | |
|---|---|
| 型式 | ESS-300 |
| 電源 | 三相200V 50/60Hz 4.0kVA(20A) |
| 消費電力 | 定格電力:174W 待機時:60Wh(0.3A) (季節によって変動します) |
| 寸法(WxDxH) | 2016×800×1700mm |
| 酸化還元電位 | 酸性電解水:約1000mV アルカリ性電解水:約-800mV(生成時) |
| 酸性側有効塩素濃度 | 20~70mg/kg(現地水質により調整) |
| 生成量 | 酸性電解水:約5.0L/min アルカリ性電解水:約5.0L/min(調整可) |
| 送水能力 | 約酸性電解水:約30L/min アルカリ性電解水:約30L/min (揚程・取水箇所数により変動) |
| 貯水タンク | 酸性電解水:約300L アルカリ性電解水:約300L |
| 製品重量 | 乾燥重量:約475kg 満水時:約1075kg |
| 給水 | 上水道(給水圧0.2~1.0MPa) |
| 使用温度範囲 | -5℃~35℃ |
| 設置場所 | 屋外(アンカーボルトによる固定) |
| 備考 | 取水口、洗濯機追加接続の場合は、 別途お見積もりいたします。 |
ESS-ZERO
貯留0Lで驚きの省スペースを実現。
初めてのタンク[レス]タイプ
| ESS-ZERO | |
|---|---|
| 型式 | ESS-ZERO |
| 電源 | 単相100V 50/60Hz 1.0kVA(10A) |
| 消費電力 | 定格電力:143W 待機時:60Wh(0.3A) |
| 寸法(WxDxH) | 500×500×820mm |
| 電解水pH | 酸性電解水:約3.0 アルカリ性電解水:約12.0 |
| 酸化還元電位 | 酸性電解水:約1000mV アルカリ性電解水:約-800mV(生成時) |
| 酸性側有効塩素濃度 | 20~70mg/kg(現地水質により調整) |
| 生成量 | 酸性電解水:約5.0L/min アルカリ性電解水:約5.0L/min(調整可) |
| 製品重量 | 乾燥重量:約80kg |
| 給水 | 上水道(給水圧0.2~1.0MPa) |
| 排水 | 背圧がかからないこと |
| 使用温度範囲 | 5℃~35℃ |
| 設置場所 | 屋内(床置式、要排気設備、凍結・ 結露しない場所であること |
| 備考 | 取水口、洗濯機追加接続の場合は、 別途お見積もりいたします。 |
お問い合わせはこちらの
お問合せフォームよりお気軽にどうぞ。
)
)
)
)
)
)